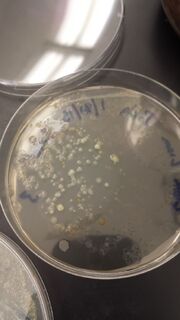

Uploads by Joshua Terao
From OpenWetWare
Jump to navigationJump to search
This special page shows all uploaded files.
| Date | Name | Thumbnail | Size | Description |
|---|---|---|---|---|
| 21:52, 27 February 2015 | 20150224 192050 (640x618).jpg (file) |  |
213 KB | |
| 03:29, 25 February 2015 | 20150224 192050.jpg (file) |  |
1.26 MB | |
| 01:48, 23 February 2015 | 20150222 203921.jpg (file) |  |
136 KB | |
| 00:29, 12 February 2015 | Lab 4 Table.jpg (file) |  |
159 KB | |
| 04:59, 5 February 2015 | Agar Plate lab 3 (1).jpg (file) |  |
2.18 MB | |
| 04:56, 5 February 2015 | Agar Plate lab 3 (4).jpg (file) |  |
1.8 MB | |
| 04:55, 5 February 2015 | Agar Plate lab 3 (3)..jpg (file) |  |
2.19 MB | |
| 04:55, 5 February 2015 | Agar Plate lab 3 (3).jpg (file) |  |
2.3 MB | |
| 04:54, 5 February 2015 | Agar Plate lab 3.jpg (file) | |
1.89 MB | |
| 04:53, 5 February 2015 | 20150128 123957.jpg (file) |  |
2.51 MB | Agar Plate lab 3 |
| 01:54, 28 January 2015 | 20150114 134043.jpg (file) |  |
6.85 MB |